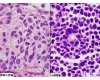
B95-8 细胞,绒猴EBV <em>转化</em>的<em>白细胞</em>

绒猴EBV转化的白细胞,B95-8细胞 绒猴EBV转化的白细胞,B95-8细胞
- 型号:绒猴EBV转化的白细胞,B95-8细胞
- 产地:上海
- 供应商:上海素尔生物科技有限公司
- 供应商报价: 1.00¥
- 标签:绒猴EBV转化的白细胞,B95-8细胞,绒猴EBV转化的白细胞,B95-8细胞价格,绒猴EBV转化的白细胞,B95-8细胞厂家
绒猴EBV转化的白细胞,B95-8细胞
大规模培养常用方法
根据动物细胞的类型,可采用贴壁培养、悬浮培养和固定化培养等三种培养方法进行大规模培养。
一、动物细胞生长特性及培养温度
1、细胞生长缓慢,易污染,培养需用抗生素
2、细胞大,无细胞壁,机械强度低,环境适应性差
3、需氧少,不耐受QL通风与搅拌
4、群体生长效应,贴壁生长(锚地依赖性)
5、培养过程产品分布细胞内外,成本高
6、原代培养细胞一般繁殖50代即退化死亡
依据在体外培养时对生长基质依赖性差异,动物细胞可分为两类:
贴壁依赖型细胞:需要附着于带适量电荷的固体或半固体表面才能生长,大多数动物细胞,包括非淋巴组织细胞和许多异倍体细胞均属于这一类。
非贴壁依赖型细胞:无需附着于固相表面即可生长,包括血液、淋巴组织细胞、许多肿瘤细胞及某些转化细胞。
培养细胞的适温度相当于各种细胞或组织取材机体的正常温度。人和哺乳动物细胞培养的适温度为35~37℃。偏离这一温度,细胞正常的代谢和生长将会受到影响,甚至死亡。总的来说,培养细胞对低温的耐力比高温高。温度不超过39℃时,细胞代谢强度与温度成正比;细胞培养置于39~40℃环境中1h,即受到一定损伤,但仍能恢复;当温度达43℃以上时,许多细胞将死亡。当温度下降到30~20℃时,细胞代谢降低,因而与培养基之间物质交换减少。首先看到的是细胞形态学的改变以及细胞从基质上脱落下来。当培养物恢复到初始的培养温度时,它们原有的形态和代谢也随之恢复到原有水平。
SUER0597(XR) T2细胞,人转HLA-2基因B细胞
SUER0598(XR) HPT-8细胞,人滋养层上皮细胞
SUER0599(XR) WPMY-1细胞,人正常前列腺基质永生化细胞
SUER0600(XR) RWPE-1细胞,人正常前列腺上皮细胞
SUER0601(XR) MCF 10A细胞,人正常乳腺上皮细胞
SUER0602(XR) ?PT67细胞,鼠逆转录酶病毒包装细胞
SUER0603(XR) LLC细胞,小鼠Lewis肺癌细胞
SUER0604(XR) MEL细胞,小鼠红白血病细胞
SUER0605(XR) ?Neuro-2a细胞,小鼠脑神经瘤细胞
SUER0606(XR) B95-8细胞,EB病毒转化的绒猴淋巴细胞
SUER0607(XR) U14-GFP细胞,GFP标记的小鼠子宫颈癌细胞
SUER0608(XR) FAT细胞,大鼠鼻咽癌细胞
SUER0609(XR) GH3细胞,大鼠垂体瘤细胞
SUER0610(XR) MMQ细胞,大鼠垂体瘤细胞
SUER0611(XR) NR8383细胞,大鼠肺泡巨噬细胞
SUER0612(XR) LLC-WRC 256细胞,大鼠腹水癌细胞
SUER0613(XR) Walker256细胞,大鼠腹水癌细胞
SUER0614(XR) CBRH-7919?细胞,大鼠肝癌细胞
SUER0615(XR) CRL-1600细胞,大鼠肝癌细胞
SUER0616(XR) R15细胞,大鼠肝癌细胞
SUER0617(XR) RH-35细胞,大鼠肝癌细胞
SUER0618(XR) H4-II-E-C3细胞,大鼠肝癌细胞
SUER0619(XR) H-4-II-E细胞,大鼠肝癌细胞
SUER0620(XR) UMR-106细胞,大鼠骨肉瘤细胞
SUER0621(XR) IR983F细胞,大鼠骨髓瘤细胞
SUER0622(XR) Y3-Ag 1.2.3细胞,大鼠骨髓瘤细胞
SUER0623(XR) C6细胞,大鼠脑胶质瘤细胞
SUER0624(XR) F98细胞,大鼠脑胶质瘤细胞
SUER0625(XR) MADB106细胞,大鼠乳腺癌细胞
SUER0626(XR) SHZ-88细胞,大鼠乳腺癌细胞
SUER0627(XR) PC-12细胞,大鼠肾上腺嗜铬瘤细胞
SUER0628(XR) PC-12(低分化)细胞,大鼠肾上腺嗜铬瘤(低分化)细胞
SUER0629(XR) PC-12(高分化)细胞,大鼠肾上腺嗜铬瘤(高分化)细胞
SUER0630(XR) RBL-2H3细胞,大鼠嗜碱性白血病
SUER0631(XR) RBL-1细胞,大鼠嗜碱性粒性白血病
SUER0632(XR) RIN-m5f细胞,大鼠胰岛β瘤细胞
SUER0633(XR) INS-1细胞,大鼠胰岛瘤细胞
SUER0634(XR) TMNE细胞,化学转化小鼠鼻咽上皮细胞
SUER0635(XR) DT40细胞,鸡淋巴瘤细胞
SUER0636(XR) DH82细胞,犬巨噬(狗肾恶性组织增生症)细胞
SUER0637(XR) P815*细胞,鼠肥大瘤细胞
SUER0638(XR) MCA-RH7777细胞,鼠肝癌细胞
SUER0639(XR) J558L细胞,鼠骨髓瘤细胞
SUER0640(XR) CMT93细胞,鼠结肠癌细胞
SUER0641(XR) WEHI 164细胞,鼠纤维肉瘤细胞
SUER0642(XR) ?SH-2,3,4?细胞,鼠杂交瘤细胞
SUER0643(XR) W6/32细胞,小鼠B杂交瘤细胞
SUER0644(XR) LM9细胞,小鼠HGPRT基因缺陷型骨肉瘤细胞
SUER0645(XR) LLC1[LL/2]细胞,小鼠Lewis肺癌细胞
SUER0646(XR) LLC-RFP-puro细胞,小鼠Lewis肺癌细胞
SUER0647(XR) E.G7-OVA细胞,小鼠T淋巴瘤细胞
SUER0648(XR) PK136细胞,小鼠X小鼠细胞
SUER0649(XR) EAC 细胞,小鼠艾氏腹水癌细胞
SUER0650(XR) L1210细胞,小鼠白血病细胞
SUER0651(XR) M1细胞,小鼠白血病细胞
SUER0652(XR) P388细胞,小鼠白血病细胞
SUER0653(XR) L6565细胞,小鼠白血病克隆系细胞
SUER0654(XR) AtT-20细胞,小鼠垂体瘤细胞
SUER0655(XR) Raw-Blue细胞,小鼠单核白血病细胞
SUER0656(XR) J774A.1细胞,小鼠单核巨噬细胞
SUER0657(XR) RAW 264.7细胞,小鼠单核巨噬白血病细胞
SUER0658(XR) P815细胞,小鼠肥大瘤细胞
SUER0659(XR) LA795细胞,小鼠肺腺癌细胞
SUER0660(XR) S-180细胞,小鼠腹水瘤/小鼠肉瘤细胞
SUER0661(XR) H22细胞,小鼠肝癌细胞
SUER0662(XR) Hepa 1-6细胞,小鼠肝癌细胞
SUER0663(XR) MH134细胞,小鼠肝癌细胞
SUER0664(XR) MLTC-1细胞,小鼠睾丸间质瘤细胞
SUER0665(XR) CRL-2836细胞,小鼠骨肉瘤成骨细胞
SUER0666(XR) K7M2 wt细胞,小鼠骨肉瘤成骨细胞
SUER0667(XR) FO细胞,小鼠骨髓瘤细胞
SUER0668(XR) P3/NSI/1-Ag4-1 [NS-1]细胞,小鼠骨髓瘤细胞
SUER0669(XR) P3X63Ag8细胞,小鼠骨髓瘤细胞
SUER0670(XR) P3X63Ag8.653细胞,小鼠骨髓瘤细胞
SUER0671(XR) SP2/0细胞,小鼠骨髓瘤细胞
SUER0672(XR) Sp2/0-Ag14细胞,小鼠骨髓瘤细胞
SUER0673(XR) B16细胞,小鼠黑色素瘤细胞
SUER0674(XR) B16/??CRL-6323细胞,小鼠黑色素瘤细胞
SUER0675(XR) B16-F0细胞,小鼠黑色素瘤细胞
SUER0676(XR) B16-F1细胞,小鼠黑色素瘤细胞
SUER0677(XR) Yac-1细胞,小鼠红白血病细胞
SUER0678(XR) F9细胞,小鼠畸胎瘤细胞
SUER0679(XR) P19细胞,小鼠畸胎瘤细胞
SUER0680(XR) F9细胞,小鼠畸胎瘤/小鼠胚胎癌细胞
绒猴EBV转化的白细胞,B95-8细胞
二、贴壁培养(attachment culture)是指细胞贴附在一定的固相表面进行的培养。
1、生长特性:贴壁依赖型细胞在培养时要贴附于培养(瓶)器皿壁上,细胞一经贴壁就迅速铺展,然后开始有丝分裂,并很快进入对数生长期。一般数天后就铺满培养表面,并形成致密的细胞单层。
2、贴壁培养的优点:
容易更换培养液;细胞紧密黏附于固相表面,可直接倾去旧培养液,清洗后直接加入新培养液。
容易采用灌注培养,从而达到提高细胞密度的目的;因细胞固定表面,不需过滤系统。
当细胞贴壁于生长基质时,很多细胞将更有效的表达一种产品。
同一设备可采用不同的培养液/细胞的比例。
适用于所有类型细胞。
3、贴壁培养的缺点:与悬浮培养法相比
扩大培养比较困难,投资大;
占地面积大;
不能有效监测细胞的生长;
4、细胞贴壁的表面:要求具有净阳电荷和高度表面活性。对微载体而言还要求具一定电荷密度;若为有机物表面,必须具有亲水性,并带阳电荷。
5、贴壁培养系统:主要有转瓶、中空纤维(后面ZT介绍)、玻璃珠、微载体系统(后面介绍)等。
转瓶培养系统:培养贴壁依赖型细胞初采用转瓶系统培养。转瓶培养一般用于小量培养到大规模培养的过渡阶段,或作为生物反应器接种细胞准备的一条途径。细胞接种在旋转的圆筒形培养器-转瓶中,培养过程中转瓶不断旋转,使细胞交替接触培养液和空气,从而提供较好的传质和传热条件。
转瓶培养具有结构简单,投资少,技术成熟,重复性好,放大只需简单的增加转瓶数量等优点。 但也有其缺点:劳动强度大,占地空间大,单位体积提供细胞生长的表面积小,细胞生长密度低,培养时监测和控制环境条件受到限制等。 现在使用的转瓶培养系统包括二氧化碳培养箱和转瓶机两类。
反应器贴壁培养 此种培养方式中,细胞贴附于固定的表面生长,不因为搅拌而跟随培养液一起流动,因此比较容易更换培养液,不需要特殊的分离细胞和培养液的设备,可以采用灌流培养获得高细胞密度,能有效地获得一种产品;但扩大规模较难,不能直接监控细胞的生长情况,故多用于制备用量较小、价值高的生物药品。
CelliGen、CelliGen PlusTM和Bioflo3000反应器是常用的贴壁培养式生物反应器,用于细胞贴壁培养时可用篮式搅拌系统和圆盘状载体。此载体是直径6毫米无纺聚酯纤维圆片,具很高表面积与体积比(1200cm2/g),利于获得高细胞密度。篮式搅拌系统和载体培养是目前贴壁细胞培养使用多方式,用于杂交瘤细胞、Hela细胞、293细胞、CHO细胞及其它细胞培养。此种方式培养细胞,细胞接种后贴壁快。
绒猴EBV转化的白细胞,B95-8细胞
![[细胞及相关培养] ATCC引进细胞 B95-8(EBV <em>转化</em>的绒猴<em>白细胞</em>)](https://item.yiqi.com/pic/CovPic/1/201082410840478.jpg)